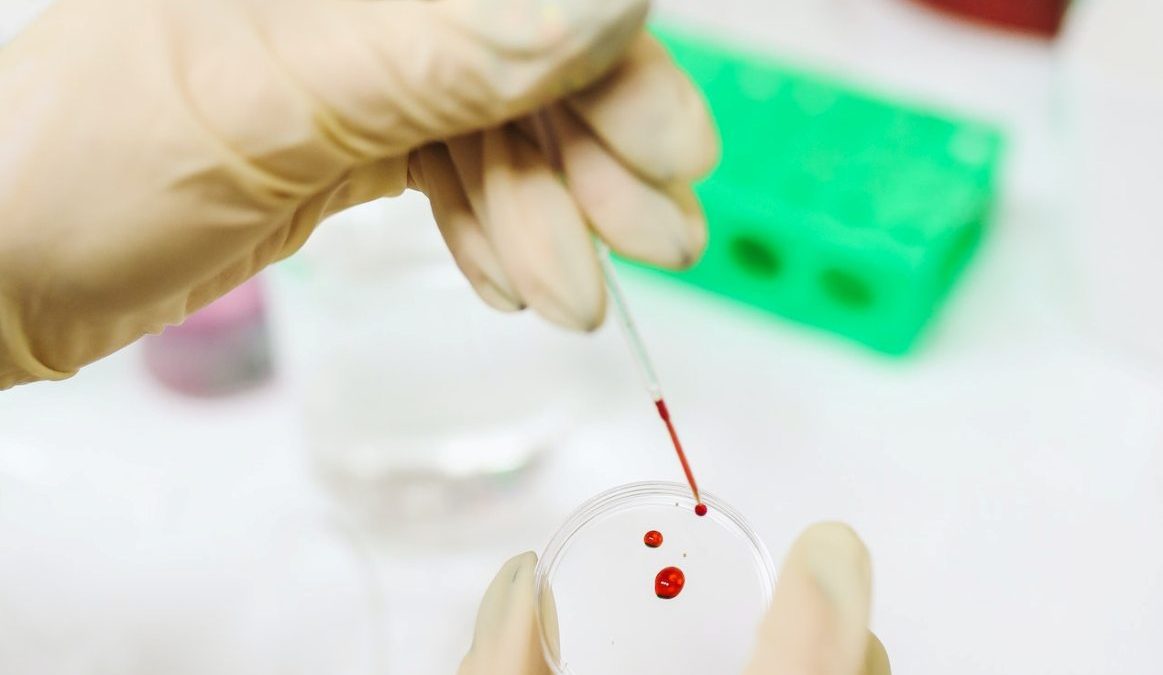
pexels-polina-tankilevitch-3735705

Uma análise de sangue pode vir a detetar até 50 tipos de cancro em pessoas ainda não diagnosticadas e sem sintomas da doença, de acordo com uma investigação apresentada esta segunda-feira, 12 de setembro, no Congresso da Sociedade Europeia de Oncologia Médica, em Paris.
O estudo, coordenado pela oncologista Deborah Schrag, apresenta-se como pioneiro no diagnóstico precoce de cancro, através de um teste de que deteta se há presença no sangue de ADN tumoral circulante, derivado do tumor e presente na corrente sanguínea mesmo antes de haver sinais da doença nos pacientes.
A investigação, realizada por oncologistas do Memorial Sloan Kettering Câncer Center (MSKCC) de Nova Iorque, baseia os seus resultados numa análise de sangue realizada em 6.621 pessoas com mais de 50 anos sem diagnóstico de cancro ou sintomas da doença.
Praticamente 99% do universo testado deu resultado negativo, ou seja, não tinha sinais de cancro, enquanto em 1,4% foram detetados sinais da doença. Ainda assim, entre esses 1,4% apenas 38% viu confirmado o diagnóstico num teste posterior.
Com estes resultados, os oncologistas entendem que a deteção precoce do cancro com um simples teste de sangue abre uma nova era para despistar a presença da doença e melhorar as taxas de mortalidade por cancro, assim como a morbilidade, mas não a incidência.
Defendem que 38% de resultados positivos naqueles pacientes é uma percentagem “boa” e um passo importante para a deteção precoce com esta ferramenta, enquanto o facto de o teste ser capaz de detetar 99% de resultados negativos supõe uma “excelente” taxa e demonstra a capacidade do teste em descartar a presença do tumor.
Depois do teste positivo levou, em média, menos de dois meses a confirmar o diagnóstico, em caso de confirmação de cancro, e cerca de três meses, quando o diagnóstico não se confirmou, sobretudo porque os médicos optaram por fazer estudos de imagem e repeti-los uma segunda vez meses mais tarde.
Uma desvantagem do teste é que os falsos positivos podem levar a uma série de procedimentos invasivos para o paciente, como endoscopias ou biópsias, mas poucos participantes no estudo os que requereram.
Isso, diz a investigação, deveria ajudar a dissipar a preocupação de que estes testes possam causar dano ao originar procedimentos desnecessários em pessoas que se encontram bem.
Os oncologistas sublinham também a importância deste tipo de teste para o diagnóstico de cancros como o pâncreas, intestino delgado ou estômago, para os quais não existem opções de rastreio generalizadas.
LUSA


